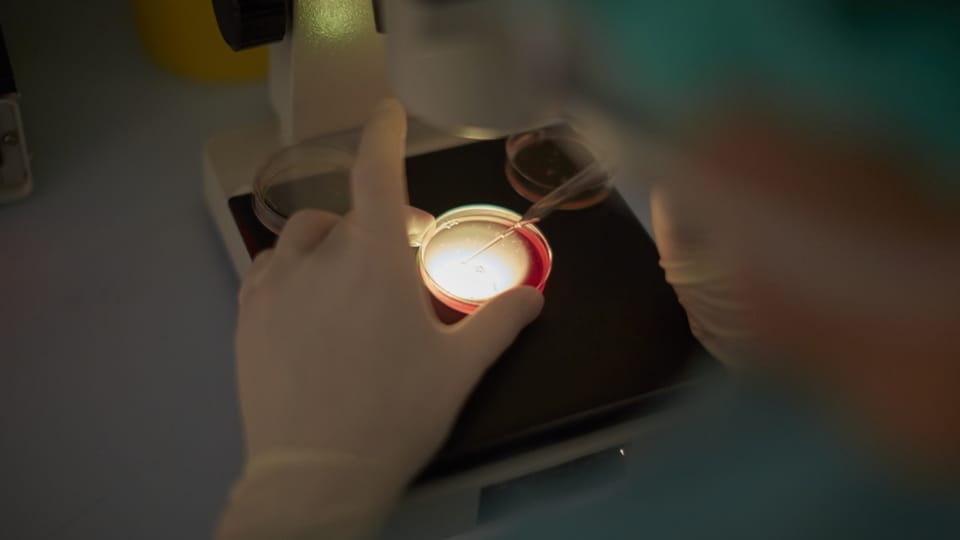
Parlament spricht sich für Legalisierung der Eizellenspende aus

Was möchte die Motion «Eizellenspende erlauben»? Die Eizellenspende soll in Zukunft für Ehepaare erlaubt sein, wenn die Unfruchtbarkeit bei der Frau liegt. Begründet wird es mit der Gleichbehandlung und dem Verweis, dass viele europäische Länder die Eizellenspende erlauben und Betroffene sonst einfach ins Ausland reisen für die Behandlung.
Bei einer Eizellenspende käme eine Eizelle zum Einsatz, die vorher einer anderen Frau als Spenderin entnommen worden ist. Im Gegensatz zu einer Samenspende – dem Ejakulat – bedingt eine Eizellenspende ein aufwändigeres Verfahren – begonnen mit einer Hormonbehandlung für die Eireifung bis zur Entnahme der Eizellen mittels Operation.
Der Nationalrat hat der Motion zugestimmt, die vorberatende Kommission des Ständerats nur knapp. Der Bundesrat ist dagegen, weil er diese und weitere Fragen klären will, in einer allfälligen Revision des Fortpflanzungsmedizingesetzes zu einem späteren Zeitpunkt.
Wer hat Zugang zur Fortpflanzungsmedizin? Die Schweiz regelt hier im Vergleich zum europäischen Ausland restriktiv. Zugang haben heterosexuelle Paare in stabiler Beziehung, welche auf natürlichem Weg keine Kinder kriegen oder welche eine schwere Krankheit vererben können. Pro Jahr nehmen rund 6000 Paare die medizinisch unterstützte Fortpflanzung wahr. Nach solchen Verfahren kommen jährlich rund 2000 Kinder zur Welt. Mit der «Ehe für alle» haben seit Mitte 2022 auch weibliche Ehepaare mit der Samenspende Zugang zur Fortpflanzungsmedizin.
Welches sind die häufigsten Verfahren in der Schweiz? Am häufigsten kommen die sogenannte In-Vitro-Fertilisation, IVF, und die Insemination zum Einsatz. Beim IVF-Verfahren werden Ei- und Samenzelle im Labor zusammengebracht und anschliessend in die Gebärmutter eingesetzt. Bei der Insemination werden die Samenzellen in den Körper eingeführt, wo es dann zur Befruchtung der Eizelle kommen soll.
Welche Verfahren sind in der Schweiz verboten? In der Schweiz sind die Leihmutterschaft, die Eizellen- und die Embryonenspende verboten (nach der Kernverschmelzung beider Keimzellen spricht die Fachwelt von Embryo). Das Parlament diskutiert in der Herbstsession über die Eizellenspende. Der Bundesrat möchte sie nicht isoliert betrachten, sondern später, im Rahmen des Fortpflanzungsmedizin-Gesetzes, das derzeit evaluiert wird.
Wie ist die Samenspende geregelt? Die Samenspende ist nur bei verheirateten Paaren zulässig, seit Mitte 2022 auch für lesbische Paare mit Trauschein. Seit 2001 sind keine anonymen Samenspenden mehr erlaubt. Inzwischen zählt die Schweiz gut 810 registrierte Samenspender. Seit 2001 sind rund 4400 Kinder mit einer Samenspende gezeugt worden. Mit 18 Jahren haben sie das Recht zu erfahren, wer ihr biologischer Vater ist. Die Nationale Ethikkommission hat 2019 empfohlen, die Samenspende auch für unverheiratete und gleichgeschlechtliche Paare sowie für alleinstehende Frauen zugänglich zu machen.
Wie lange dürfen Keimzellen eingefroren sein? Jede und jeder kann seine Keimzellen und Gewebe konservieren lassen – aus medizinischen Gründen, wegen einer Chemotherapie etwa oder um die fruchtbare Phase zu verlängern. Ei- und Samenzellen dürfen in der Regel maximal zehn Jahre aufbewahrt bleiben. Der Bund gibt per Ende 2020 insgesamt gut 1600 Personen an, welche Keimzellen oder Gewebe eingefroren haben.